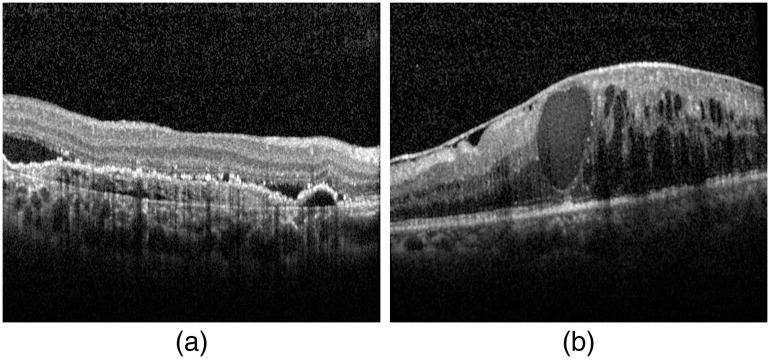

基于二维特征图和具有注意力机制的卷积神经网络的 OCT 容积自动黄斑疾病诊断。
Automatic diagnosis of macular diseases from OCT volume based on its two-dimensional feature map and convolutional neural network with attention mechanism.
机构信息
Tsinghua University, Department of Computer Science and Technology, Beijing, China.
出版信息
J Biomed Opt. 2020 Sep;25(9). doi: 10.1117/1.JBO.25.9.096004.
SIGNIFICANCE
Automatic and accurate classification of three-dimensional (3-D) retinal optical coherence tomography (OCT) images is essential for assisting ophthalmologist in the diagnosis and grading of macular diseases. Therefore, more effective OCT volume classification for automatic recognition of macular diseases is needed.
AIM
For OCT volumes in which only OCT volume-level labels are known, OCT volume classifiers based on its global feature and deep learning are designed, validated, and compared with other methods.
APPROACH
We present a general framework to classify OCT volume for automatic recognizing macular diseases. The architecture of the framework consists of three modules: B-scan feature extractor, two-dimensional (2-D) feature map generation, and volume-level classifier. Our architecture could address OCT volume classification using two 2-D image machine learning classification algorithms. Specifically, a convolutional neural network (CNN) model is trained and used as a B-scan feature extractor to construct a 2-D feature map of an OCT volume and volume-level classifiers such as support vector machine and CNN with/without attention mechanism for 2-D feature maps are described.
RESULTS
Our proposed methods are validated on the publicly available Duke dataset, which consists of 269 intermediate age-related macular degeneration (AMD) volumes and 115 normal volumes. Fivefold cross-validation was done, and average accuracy, sensitivity, and specificity of 98.17%, 99.26%, and 95.65%, respectively, are achieved. The experiments show that our methods outperform the state-of-the-art methods. Our methods are also validated on our private clinical OCT volume dataset, consisting of 448 AMD volumes and 462 diabetic macular edema volumes.
CONCLUSIONS
We present a general framework of OCT volume classification based on its 2-D feature map and CNN with attention mechanism and describe its implementation schemes. Our proposed methods could classify OCT volumes automatically and effectively with high accuracy, and they are a potential practical tool for screening of ophthalmic diseases from OCT volume.
意义
自动且准确地对三维(3-D)视网膜光相干断层扫描(OCT)图像进行分类对于辅助眼科医生诊断和分级黄斑疾病至关重要。因此,需要更有效的 OCT 体积分类方法来实现自动识别黄斑疾病。
目的
对于仅具有 OCT 体积级别标签的 OCT 体积,设计、验证并比较了基于其全局特征和深度学习的 OCT 体积分类器。
方法
我们提出了一种用于自动识别黄斑疾病的 OCT 体积分类通用框架。该框架的架构由三个模块组成:B 扫描特征提取器、二维(2-D)特征图生成和体积级别分类器。我们的架构可以使用两种 2-D 图像机器学习分类算法来解决 OCT 体积分类问题。具体来说,训练并使用卷积神经网络(CNN)模型作为 B 扫描特征提取器来构建 OCT 体积的 2-D 特征图,并描述了具有/不具有注意力机制的 2-D 特征图的体积级别分类器,如支持向量机和 CNN。
结果
我们的方法在包含 269 个中间年龄相关性黄斑变性(AMD)体积和 115 个正常体积的公开可用的 Duke 数据集上进行了验证。进行了五折交叉验证,分别获得了 98.17%、99.26%和 95.65%的平均准确率、灵敏度和特异性。实验表明,我们的方法优于最新技术方法。我们的方法还在包含 448 个 AMD 体积和 462 个糖尿病性黄斑水肿体积的私人临床 OCT 体积数据集上进行了验证。
结论
我们提出了一种基于其 2-D 特征图和具有注意力机制的 CNN 的 OCT 体积分类通用框架,并描述了其实现方案。我们提出的方法可以自动、有效地对 OCT 体积进行分类,具有很高的准确率,并且是从 OCT 体积筛选眼科疾病的潜在实用工具。